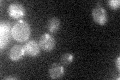
YGR257C
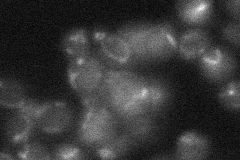
YGR257C
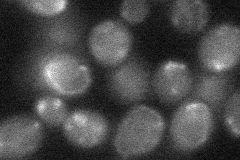
YGR257C
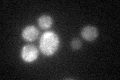
YGR257C

View description
Mitochondrial protein of the mitochondrial carrier family, involved in activating mitochondrial Sod2p probably by facilitating insertion of an essential manganese cofactor
Localization:
Intensity:
Fold change:
Significance:
-
C’ GFP library in SD
mitochondria17.95 -
N' NOP1pr-GFP in SD

below threshold0 -
N' TEF2pr-mCherry in SD

mitochondria43.3322 -
N' NATIVEpr-GFP in SD
punctate,mitochondria20.2232 -
N' TEF2pr-VC and Cyto-VN in SD
mitochondria27.7151 -
C’ GFP library in SD+DTT
mitochondria19.721.09No -
C’ GFP library in SD+H2O2

mitochondria17.790.99No -
C’ GFP library in Starvation Media

mitochondria15.860.88No -
C’ GFP library on the background of Pup2-DaMP

mitochondria -
C’ GFP library on the background of CCT mutant

mitochondria16.43950.9156No
